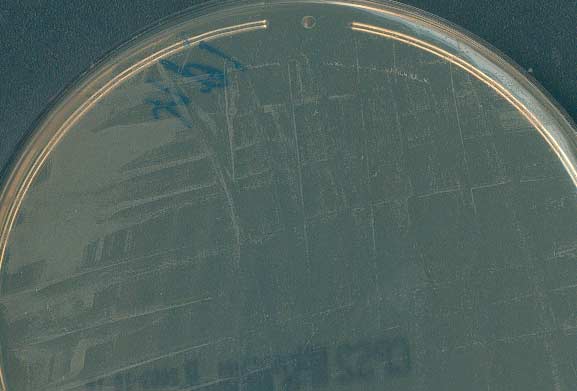
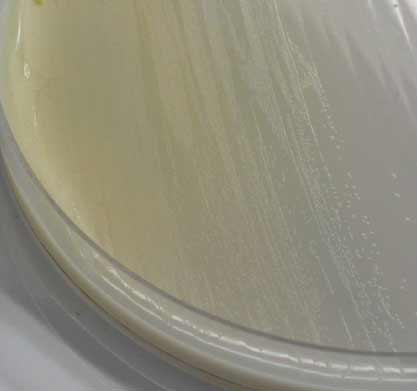

- Voici les aspects morphologiques des cultures obtenues sur le milieu CPS après 24 heures (haut) et 48 heures (bas) d'incubation à 37°C en aérobiose :

- Le prélèvement a été aussi ensemencé sur un autre milieu chromogène Uriselect® incubée à 37 °C s pendant 48 heures.

- Compte tenu de ces aspects de culture inhabituels avec le résultat de la coloration de Gram (coques à Gram-positif en amas), un isolement a été obtenu sur la gélose au sang frais dont voici l'aspect après 36 heures d'incubation à 37°C sous 5% de CO2:

- Parmi les tests d'orientation rapide est effectuée la recherche de la catalase qui est négative ainsi que celle de l'oxydase.
- D'autres caractères d'identification sont recherchés après ensemencement d'une galerie d'une part, API20 STREP et d'autre part API CORYNE comme montrés ci-dessous:
|
|
|
|
|



